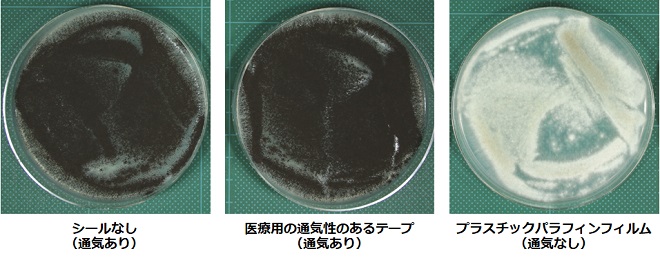
図１　NBRC 9455の通気性の違いによる胞子形成の違い（PDA培地、平板、25℃、3日間培養）

NBRCニュース 第62号
◆◇◆ ━━━━━━━━━━━━━━━━━━━━━━━━━━━━━━━━ ◆◇◆
NBRCニュース No. 62(2020.3.31)
◆◇◆ ━━━━━━━━━━━━━━━━━━━━━━━━━━━━━━━━ ◆◇◆
この度の新型コロナウイルス感染症において亡くなられた方々に謹んでお悔やみ申し上
げます。また、罹患されている方々、感染拡大により生活に影響を受けられている方々に
心よりお見舞い申し上げます。NBRCでも本件の影響により、NBRC株等の発送を延期させて
いただく可能性がございます。発送に関する最新の情報は6.に掲載しているウェブペー
ジをご確認ください。
NBRCニュース第62号をお届けします。最後までお読みいただければ幸いです。
================================================================================
内容
================================================================================
1.新たにご利用可能となった微生物株
2.微生物の培養法(22)
日本薬局方規定菌Aspergillus brasiliensis NBRC 9455に胞子を形成させるための
ちょっとしたコツ
3.NBRCのウェブページで提供している微生物画像の追加のお知らせ
4.イノベーション共創プログラム「NICE」開始のお知らせ
5.各種手数料の改定のお知らせ(再掲)
6.GW期間中のNBRC株・DNAリソース・NBRC微生物カクテルの発送休止について
================================================================================
1.新たにご利用可能となった微生物株
================================================================================
◆ NBRC株
酵母43株、糸状菌19株、細菌36株、微細藻類1株、ゲノムDNA6種類が新たにご利用可能
となりました。
酵母では、2種類のリパーゼを分泌し、そのうち一方は低温の4℃でも活性を有するとい
うユニークな特徴の北海道利尻島産Wickerhamomyces psychrolipolyticus NBRC 113263
およびNBRC 113264を公開しました。
細菌では、油で汚染された土壌(北海道にて採取)から分離された"Aerosticca soli"
NBRC 112897を公開しました。また、イチゴから分離されたLactobacillus plantarum
NBRC 114369、韓国のキムチから分離されたLactococcus kimchii NBRC 113348を公開しま
した。
【詳細】 https://www.nite.go.jp/nbrc/cultures/nbrc/new_strain/new_dna.html
【リパーゼ分泌酵母に関する参考文献】
Shimizu, Konno, Tomita (2020). Int. J. Syst. Evol. Microbiol. 70, 1158-1165.
◆ RD株
これまでに公開した新潟薬科大学より譲り受けた油脂酵母(301株)に加え、さらに
Lipomyces属26株の提供を開始しました。
【詳細】 https://www.nite.go.jp/nbrc/cultures/rd/new_rd.html
【RD株リスト】 https://www.nite.go.jp/nbrc/cultures/rd/available_rd_list.html
【新潟薬科大学より譲り受けた油脂酵母Lipomyces属等菌株の紹介】
https://www.nite.go.jp/nbrc/cultures/others/nbrcnews/news_vol60.html#news60_3
================================================================================
2.微生物の培養法(22)
日本薬局方規定菌Aspergillus brasiliensis NBRC 9455に胞子を形成させるための
ちょっとしたコツ (山口 薫)
================================================================================
NBRCの糸状菌でもっとも分譲依頼のある菌株はAspergillus brasiliensis NBRC 9455で
す。日本薬局方に規定されており、医薬品や化粧品等の微生物限度試験や保存効力試験等
に広く使用されています。これらの試験では胞子懸濁液を使用するため、本菌株に胞子を
形成させることはとても重要です。本菌株の胞子は黒いため、胞子が旺盛に形成されると
コロニーの表面が黒色になりますが、ユーザーのみなさまからはコロニー表面が白くなる
場合がある、胞子形成能を維持したまま保存するにはどうしたらよいか等、胞子形成に関
するお問い合わせをいただくことがあります。そこで、ちょっとしたコツをご紹介いたし
ます。
NBRCの試験では、本菌株の胞子形成には培養時の通気性が重要であることがわかりまし
た。ポテトデキストロース寒天培地(PDA)の平板培地に植菌したシャーレを、(1)シー
ルなし、(2)医療用の通気性のあるテープ(マイクロポア(TM)サージカルテープ、3M
社製)でシール、(3)プラスチックパラフィンフィルムでシール、の3条件にて3日間培
養すると、シールなしと通気性のあるテープでシールした場合は黒い胞子を形成しました
が、プラスチックパラフィンフィルムでシールしたものは胞子形成が遅く、コロニーは白
いままでした。
さらに本菌株をPDAのスラント(斜面培地)に植菌し、(1)シリコセン(信越ポリマー
社製)※でフタをした試験管(通気あり)、(2)プラスチックパラフィンフィルムでフ
タをした試験管(通気なし)、の2条件にて3日間培養して比較しました。この時、通気の
ある、なしの効果をみるために、スラントの口に近い部分に脱酸素剤(エージレス、三菱
ガス化学社製)を設置し、スラント内の酸素を無くしました。培養の結果、シリコセンで
フタをした方は黒い胞子を形成しましたが、プラスチックパラフィンフィルムでフタをし
た方は、白いコロニーのままか、菌糸成長もしない状態でした。脱酸素剤とともに一緒に
入れた酸素検知剤(エージレスアイ、三菱ガス化学社製)はシリコセンの方では酸素濃度
が0.5%以上であることを示す青色になっていましたが、プラスチックパラフィンフィルム
でフタをした方では、酸素濃度が0.1~0.5%であることを示すピンク色~紫色であり、酸
素濃度が低い場合は胞子形成能が低下することがわかりました。
これらの結果より、糸状菌の平板培養では通常はプラスチックパラフィンフィルムで
シールをしますが、NBRC 9455に胞子を形成させたい場合は、コロニーが胞子によって黒
くなるまではフィルムを巻かずに通気性を維持して培養する方が良いということがわかり
ました。他の菌株とのコンタミネーションを防ぐためには、シャーレをプラスチック容器
等に入れて培養すると良いです。また、本菌株では胞子形成能が失われた白いコロニーが
ある程度出現することがわかっています。胞子形成能を持った菌株を維持するには、なる
べく黒い胞子を形成している部分を保存または継代してください。
※シリコーン製でスポンジ様のものをシリコセン(通気あり)、シリコーン製で消しゴム
様のものをシリコ栓(通気無し)といいます。
図1 NBRC 9455の通気性の違いによる胞子形成の違い(PDA培地、平板、25℃、3日間培養)
図1 NBRC 9455の通気性の違いによる胞子形成の違い(PDA培地、平板、25℃、3日間培養)
図2 NBRC 9455の通気性の違いによる胞子形成の違い
(PDA培地、斜面、25℃、3日間培養)
酸素検知剤は酸素濃度0.5%以上が青色、0.1%以下はピンク色、
0.1~0.5%の間は青色とピンク色の中間色を示す
================================================================================ 3.NBRCのウェブページで提供している微生物画像の追加のお知らせ ================================================================================ NBRCのウェブページより、保有する微生物の画像を提供しています。地道にラインナッ プを増やしており、新たに以下の種の画像を追加しました。ビフィズス菌やグルタミン酸 生産菌、部屋干しの洗濯物の臭いの原因菌として知られるモラクセラ細菌の仲間などの画 像もあります。微生物に関するプレゼンや説明資料等にぜひご活用ください。 グルタミン酸生産菌(Corynebacterium glutamicum NBRC 12168) ビフィズス菌(Bifidobacterium bifidum NBRC 100015) 根粒菌(Rhizobium radiobacter NBRC 14554) メチロバクテリウム細菌(Methylobacterium persicinum NBRC 103628) モラクセラ細菌(Moraxella osloensis NBRC 111460) 【URL】 https://www.nite.go.jp/nbrc/cultures/support/mphoto_consent.html ================================================================================ 4.イノベーション共創プログラム「NICE」開始のお知らせ ================================================================================ NITEは、皆様の製品・サービス創出時における研究開発上の課題や新技術の社会実装に おける課題を解決するためのプログラム「NICE」(NITE Innovative Collaboration Expert)を新たに立ち上げました。NITE全部門が一体となったオープン・イノベーション の推進により、皆様の新たな製品・サービスの創出を促進します。微生物に関するご要望 にとどまらず、NICEに関するご相談やご提案がございましたらお気軽にご連絡ください。 ※NICEに関する詳細は以下のウェブページでご確認ください。 【詳細】 https://www.nite.go.jp/nite/innovation/nice.html ================================================================================ 5.各種手数料の改定のお知らせ(再掲) ================================================================================ NBRCでは、「独立行政法人の事務・事業の見直しの基本方針(平成22年12月7日閣議決 定)※」に基づき受益と負担の適正化を考慮し、実費を勘案した手数料を利用者の皆様に ご負担いただいております。この度、直近の実費に基づき見直した結果、2020年4月1日に 手数料を改定いたします。 新しい手数料の額などの詳細は、以下のURLよりご確認ください。今後も円滑な事業継 続に努めて参りますので、利用者の皆様にはご理解とご協力を賜りますよう、何卒宜しく お願い申し上げます。 手数料を改定する業務 ◆NBRC株の分譲 ◆DNAリソースの分譲 ◆証明書の発行 ◆継続保管 【NBRCの手数料改定に係るお知らせおよび手数料一覧】 https://www.nite.go.jp/nbrc/cultures/information/amendment_of_fee.html https://www.nite.go.jp/nbrc/cultures/charge/fee.html ※独立行政法人の事務・事業の見直しの基本方針(平成22年12月7日閣議決定)」におい て、「特定の者が検査料、授業料、利用料、配布価格、技術指導料等を負担して実施する 事業については、受益者の負担を適正なものとする観点から、その負担の考え方を整理し、 これに基づき、国民生活への影響に配慮しつつ検査料等の見直しを行う。」とされており ます。 ================================================================================ 6.GW期間中のNBRC株・DNAリソース・NBRC微生物カクテルの発送休止について ================================================================================ NBRCでは以下の期間中、発送を休止させていただきます。 ◆NBRC株・DNAリソース 発送休止期間:2020年4月24日(金) ~ 5月7日(木) 発送予定: 4月20日(月)午後 ~ 4月26日(日) 受付分 → 5月 8日(金)発送 4月27日(月) ~ 5月 6日(水) 受付分 → 5月12日(火)発送 5月 7日(木) ~ 5月11日(月)午前受付分 → 5月14日(木)以降順次発送 ※分譲受付が集中する場合や分譲標品の形態により、発送日が遅れることがございます。 ◆NBRC微生物カクテル 発送休止期間:2020年 4月29日(水) ~ 5月10日(日) 【詳細】 https://www.nite.go.jp/nbrc/cultures/information/holiday.html ※新型コロナウイルス感染症の影響で、発送を延期させていただく可能性がございます。 発送に関する最新の情報も上のウェブページをご確認ください。 ================================================================================ 編集後記 ================================================================================ 私は現在、夕食のみの1日1食を実践中です(3時のおやつは対象外)。きっかけは昼の 眠気対策です。周りの人にこの事を言うと、「身体を壊しますよ。」と精神が壊れそうな ほど言われてしまいますが・・・。 食事や栄養学に限らず、日々常識や理論はアップデートされています。昨日まで善だっ たものが今日からは悪になったり。1日30品目摂取も今は昔。現状に満足せず日々自分を アップデートし、正解のないものを探求することは、正解ありきの教育を受けてきた私に はしんどいですが、自分に合ったものを前向きにトライしようと思います。 来年度もNBRCニュースのご愛読、よろしくお願いいたします。(TA) ◆◇◆ ━━━━━━━━━━━━━━━━━━━━━━━━━━━━━━━━ ◆◇◆ ・画像付きのバックナンバーを以下のサイトに掲載しております。受信アドレス変更、 受信停止も以下のサイトからお手続きいただけます。 https://www.nite.go.jp/nbrc/cultures/others/nbrcnews/nbrcnews.html ・NBRCニュースは配信登録いただいたメールアドレスにお送りしております。 万が一間違えて配信されておりましたら、お手数ですが、下記のアドレスにご連絡 ください。 ・ご質問、転載のご要望など、NBRCニュースについてのお問い合わせは、下記のアド レスにご連絡ください。 ・掲載内容は予告なく変更することがございます。掲載内容を許可なく複製・転載さ れることを禁止します。 ・偶数月の1日(休日の場合はその前後)に配信します。第63号は2020年6月1日に配 信予定です。 編集・発行 独立行政法人製品評価技術基盤機構(NITE)バイオテクノロジーセンター(NBRC) NBRCニュース編集局(nbrcnews@nite.go.jp) ◆◇◆ ━━━━━━━━━━━━━━━━━━━━━━━━━━━━━━━━ ◆◇◆
お問い合わせ
-
独立行政法人製品評価技術基盤機構 バイオテクノロジーセンター
生物資源利用促進課
(お問い合わせはできる限りお問い合わせフォームにてお願いします) -
TEL:0438-20-5763
住所:〒292-0818 千葉県木更津市かずさ鎌足2-5-8 地図
お問い合わせフォームへ








